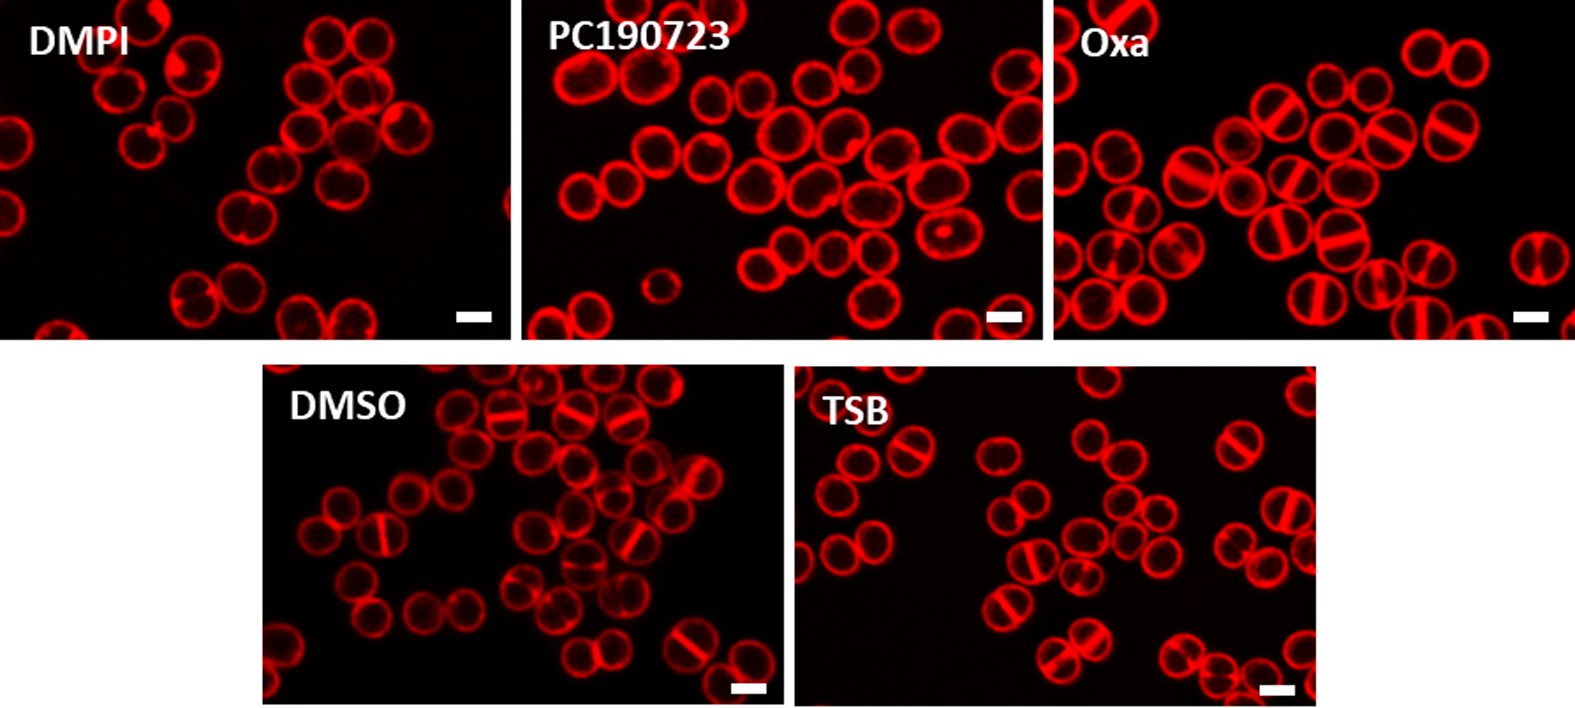
Extended Data Figure 5: Effect of antibiotics on cell-cycle progression of S. aureus.

Extended Data Figure 5: Effect of antibiotics on cell-cycle progression of S. aureus.
From: Peptidoglycan synthesis drives an FtsZ-treadmilling-independent step of cytokinesis
SIM images of Nile-Red-stained COL cells treated with DMPI, PC190723, oxacillin (Oxa), DMSO or TSB (mock-treated controls) for the duration of one cell cycle (30 min). Images are representative of three biological replicates. Scale bars, 1 μm.